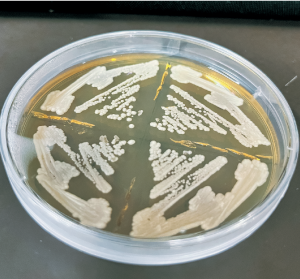

印刷
ページ番号:10756
更新日:2026年2月27日
ここから本文です。
県政スポット
県民だより奈良
2022年3月号

新型コロナワクチンの接種について
- 新型コロナワクチンの接種は、ご自身の発症や重症化の確率を減らすことが期待できるだけでなく、同居する家族や日常的に接する友人・同僚など、周りの大切な人たちの健康と命を守ることにもつながります。
- 現在、各市町村の会場を中心にワクチンの3回目接種が進められています。まだ接種がお済みでない方は、1回目、2回目接種と異なるワクチンを接種すること(交互接種)も安全性や効果について確認されていますので、接種についてご検討をお願いします。
- 加えて5~11歳の子どもにファイザー社ワクチンの1回目、2回目接種ができるようになりますので、国や自治体からの情報を確認の上、ご検討をお願いします。
- 追加(3回目)接種、子どもへの接種についての詳細は、県HPにも掲載しています。

新型コロナワクチンの追加(3回目)接種について
3回目接種後7日以内の副反応は、一部の症状が現れる確率に差があるものの、おおむね1回目、2回目接種と同じであることが確認されています。
1回目、2回目接種と同じワクチンであっても、異なるワクチンであっても、追加(3回目)接種を行うことにより、抗体価が十分上昇することが確認されています。


※武田/モデルナ社製ワクチンの追加(3回目)接種は、50μgで薬事承認されていますが、上記の研究は100μgで接種した結果です。
※抗体価は、幾何平均です。

5~11歳の子どもの新型コロナワクチン接種について
欧米の多国間共同研究では、5~11歳の子どもにファイザー社ワクチンを接種した場合の安全性と効果が報告されています。
2回目接種後、約2カ月の追跡期間において、安全性が示されました。局所に痛みや腫れ、赤みなどの症状が出ても、多くは2日以内に軽減しています。
5~11歳の子どもの2回目接種後1カ月の免疫は、16~25歳への2回目接種後1カ月の免疫と比較し同等で、2回目接種後7日以降の発症予防効果は90.7%でした。

感染症予防の効果と副反応のリスクの双方について正しい知識を持っていただいた上で、ご本人または保護者の意思に基づいて接種を判断してください。ご本人などの同意なく接種が行われることはありません。

ワクチン接種の申込手続きについては、お住まいの市町村役場が発信する情報(HP、広報誌など)をご確認ください。
- 問 県新型コロナワクチン接種推進室
- 電話 0742-27-8309
- FAX 0742-27-8086



道路を横断するとき
- 近くに横断歩道がある場所では横断歩道を利用しましょう。
- 車が来ないか左右の安全確認や遠くまでしっかり確認しましょう。
- 渡り始める前だけでなく、横断中も左右を確認しましょう。特にシニアの方は、左側からくる車にも注意しましょう。
信号機のない横断歩道を横断するとき
- 手を上げる・ドライバーに視線を送るなど合図し、横断する意思を伝えましょう。

横断歩道の近くを走るとき
- 横断歩道を横断しようとする歩行者がいるときは、手前で停止しなければなりません。
- 明らかに歩行者がいない場合以外は、横断歩道の停止位置で止まれる速度で通行しましょう。
- 横断歩道やその手前で止まっている車があるとき、そのそばを通って前方に出る前に一時停止しなければなりません。
- 横断歩道から30メートル以内の場所では、他の車を追い越したり、追い抜いたりしてはいけません。


- 問 県警察本部交通企画課
- 電話 0742-23-0110
2022(令和4)年10月1日から 一定以上の所得のある75歳以上の人の医療費の窓口負担割合が変わります!
見直しの必要性と内容








- 問 奈良県後期高齢者医療広域連合
- 電話 0744-29-8430(平日8時30分~17時15分)
- URL ssl.nara-kouiki.jp
または、お住まいの市町村の後期高齢者医療担当課
県と近畿大学が連携!柿ワイン(柿果実酒)の商品化に向けて!
県と近畿大学は、2016年に包括的連携協定を締結し、さまざまな取り組みを共同で進めています。その1つが、県産柿を使ったワインの商品化の取り組みです。
なお、今回の柿ワインの取り組みは、農林水産省の持続可能な新たなビジネスモデルの創出を支援する地域食農連携プロジェクト(LFP)推進事業も活用しています。
商品開発に向けて
奈良県は、全国第2位の柿の産地ですが、柿の加工品は干し柿やあんぽ柿などがほとんどです。新たな加工品開発は、柿の有効活用や高付加価値化、産地ブランド力向上などの点から、重要な課題でした。
そこで、奈良県と近畿大学が共同して柿ワインの商品化に向けた研究を行ってきました。
近畿大学農学部の上垣教授の研究室では、柿ワインに適した酵母の検索や製造方法など、柿ワインの商品化に向けた研究が行われてきました。

上垣教授の研究室のメンバー
柿ワインに適した酵母の検索

販売に向けて
近畿大学との研究成果を基に、泉屋(酒類卸売業者)、近畿大学農学部、堀内果実園(柿生産者)および柿生産者協議会が協力し、「柿ワイン」の商品化に向けた取り組みを進めています。

タンクに入れた原料の柿

絞りたての柿ワイン

柿ワインの商品化に取り組むメンバー
(泉屋の今西さん、堀内果実園の堀内さん)

「柿ワイン」の商品ラベルは、近畿大学文芸学部の安教授のゼミでの産学連携課題のコンペにより上村怜奈さん(3回生)のデザインが採用されました。

ラベルは、正岡子規の俳句「柿くへば鐘が鳴るなり 法隆寺」をモチーフに、ワインの味わいや飲んだ後の余韻を重厚な鐘の音で表現しています。

- 問 県豊かな食と農の振興課
- 電話 0742-27-7401
- FAX 0742-26-6211
奈良を“楽しむ”あなたのそばに― 奈良県公式スマホアプリ NARA+
どんなイベントや
おでかけスポットが
あるの?
食べたいけど、
良いところはあるかな?
どんな事業に
力を入れて
いるんだろう?
そんな疑問をこのアプリが解決します。
県内のおでかけ、グルメ、健康などの情報や、県・市町村のニュースを毎日配信中。
奈良の今がわかる!ナラプラスで新しい奈良を発見してみませんか?
スマートフォンを持っている人は、ぜひダウンロード!
女性・子育て
子育てについての悩みを解消する記事や、働く女性向けのセミナー情報など、お役立ち情報を配信中!
地域ニュース
県主要プロジェクトの動きや、健康、くらし、防災情報など、奈良のニュースをいち早くお届け!
おでかけ
おすすめスポットやお祭り、グルメ、メジャーなイベントから地域の小さなイベントまで最新情報盛りだくさん!
eブック
「県民だより奈良」や県発行の各種ジャーナルが電子書籍で読める!
バックナンバーも読めちゃう♪
アート・カルチャー
奈良の深~い歴史を学べるセミナーや、社寺での音楽イベントなど文化芸術情報を配信!
県政TV番組動画も配信中!
写真や文字では伝わらない、奈良の奥深い魅力に触れてみてください。
ダウンロード無料
Android版 play.google.com/store/apps/details?id=com.narakenkoho.cms
iOS版 apps.apple.com/us/app/narapurasu/id1125886812?l=ja&ls=1
- 問 県広報広聴課
- 電話 0742-27-8325
- FAX 0742-22-6904